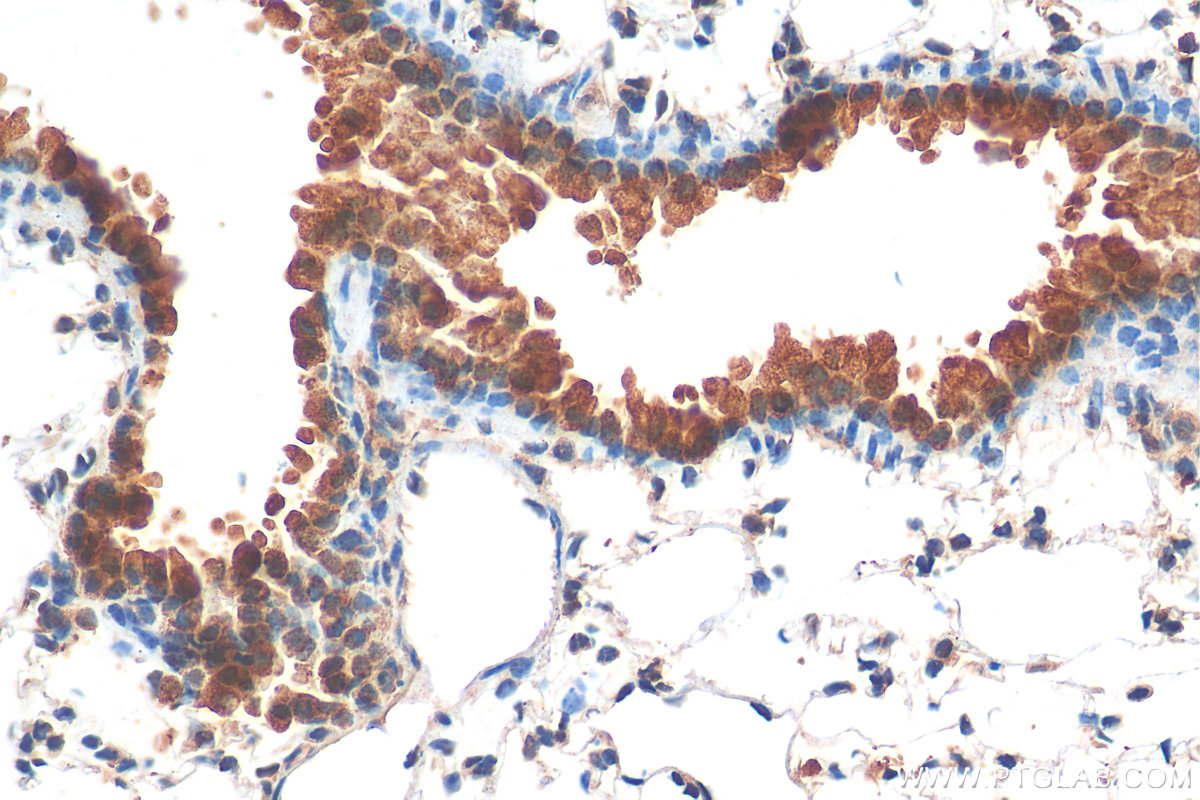

验证数据展示
经过测试的应用
| Positive IHC detected in | human kidney tissue, mouse lung tissue, human prostate cancer tissue Note: suggested antigen retrieval with TE buffer pH 9.0; (*) Alternatively, antigen retrieval may be performed with citrate buffer pH 6.0 |
推荐稀释比
| 应用 | 推荐稀释比 |
|---|---|
| Immunohistochemistry (IHC) | IHC : 1:50-1:500 |
| It is recommended that this reagent should be titrated in each testing system to obtain optimal results. | |
| Sample-dependent, Check data in validation data gallery. | |
发表文章中的应用
| IHC | See 10 publications below |
| IF | See 3 publications below |
产品信息
17353-1-AP targets TIMP2 in IHC, IF, ELISA applications and shows reactivity with human, mouse, rat samples.
| 经测试应用 | IHC, ELISA Application Description |
| 文献引用应用 | IHC, IF |
| 经测试反应性 | human, mouse, rat |
| 文献引用反应性 | human, mouse, rat, bovine |
| 免疫原 |
CatNo: Ag10051 Product name: Recombinant human TIMP2 protein Source: e coli.-derived, PET28a Tag: 6*His Domain: 6-220 aa of BC052605 Sequence: RTLRLALGLLLLATLLRPADACSCSPVHPQQAFCNADVVIRAKAVSEKEVDSGNDIYGNPIKRIQYEIKQIKMFKGPEKDIEFIYTAPSSAVCGVSLDVGGKKEYLIAGKAEGDGKMHITLCDFIVPWDTLSTTQKKSLNHRYQMGCECKITRCPMIPCYISSPDECLWMDWVTEKNINGHQAKFFACIKRSDGSCAWYRGAAPPKQEFLDIEDP 种属同源性预测 |
| 宿主/亚型 | Rabbit / IgG |
| 抗体类别 | Polyclonal |
| 产品类型 | Antibody |
| 全称 | TIMP metallopeptidase inhibitor 2 |
| 别名 | TIMP-2, CSC 21K, CSC-21K, Metalloproteinase inhibitor 2, TIMP 2 |
| 计算分子量 | 220 aa, 24 kDa |
| GenBank蛋白编号 | BC052605 |
| 基因名称 | TIMP2 |
| Gene ID (NCBI) | 7077 |
| RRID | AB_2287495 |
| 偶联类型 | Unconjugated |
| 形式 | Liquid |
| 纯化方式 | Antigen affinity purification |
| UNIPROT ID | P16035 |
| 储存缓冲液 | PBS with 0.02% sodium azide and 50% glycerol, pH 7.3. |
| 储存条件 | Store at -20°C. Stable for one year after shipment. Aliquoting is unnecessary for -20oC storage. |
背景介绍
The TIMPs are natural highly specific endogenous inhibitors of MMPs. Human TIMP family consists of four 21-28 kDa proteins known as TIMP1, TIMP2, TIMP3, and TIMP4 encoded by four paralogous genes.TIMPs are vital to the maintenance of ECM homeostasis primarily through their MMP inhibitory functions. TIMP2, a member of the TIMP family, regulates the proteolytic activity of all MMPs and is involved in cell differentiation, growth, migration, angiogenesis, and apoptosis. Urinary TIMP2 has been recently recognized as an early biomarker to predict Acute kidney injury (AKI) in critically ill patients.
实验方案
| Product Specific Protocols | |
|---|---|
| IHC protocol for TIMP2 antibody 17353-1-AP | Download protocol |
| Standard Protocols | |
|---|---|
| Click here to view our Standard Protocols |
发表文章
| Species | Application | Title |
|---|---|---|
Clin Cancer Res RAB37 Hypermethylation Regulates Metastasis and Resistance to Docetaxel-Based Induction Chemotherapy in Nasopharyngeal Carcinoma. | ||
Cell Death Dis α1,3-fucosylation of MEST promotes invasion potential of cytotrophoblast cells by activating translation initiation | ||
Int J Mol Sci PTEN Inhibitor Treatment Lowers Muscle Plasma Membrane Damage and Enhances Muscle ECM Homeostasis after High-Intensity Eccentric Exercise in Mice | ||
Int J Biol Sci TDG suppresses the migration and invasion of human colon cancer cells via the DNMT3A/TIMP2 axis. | ||
Invest Ophthalmol Vis Sci Quercetin Alleviates Scleral Remodeling Through Inhibiting the PERK-EIF2α Axis in Experiment Myopia | ||
Mar Drugs 11-epi-Sinulariolide Acetate Reduces Cell Migration and Invasion of Human Hepatocellular Carcinoma by Reducing the Activation of ERK1/2, p38MAPK and FAK/PI3K/AKT/mTOR Signaling Pathways. |